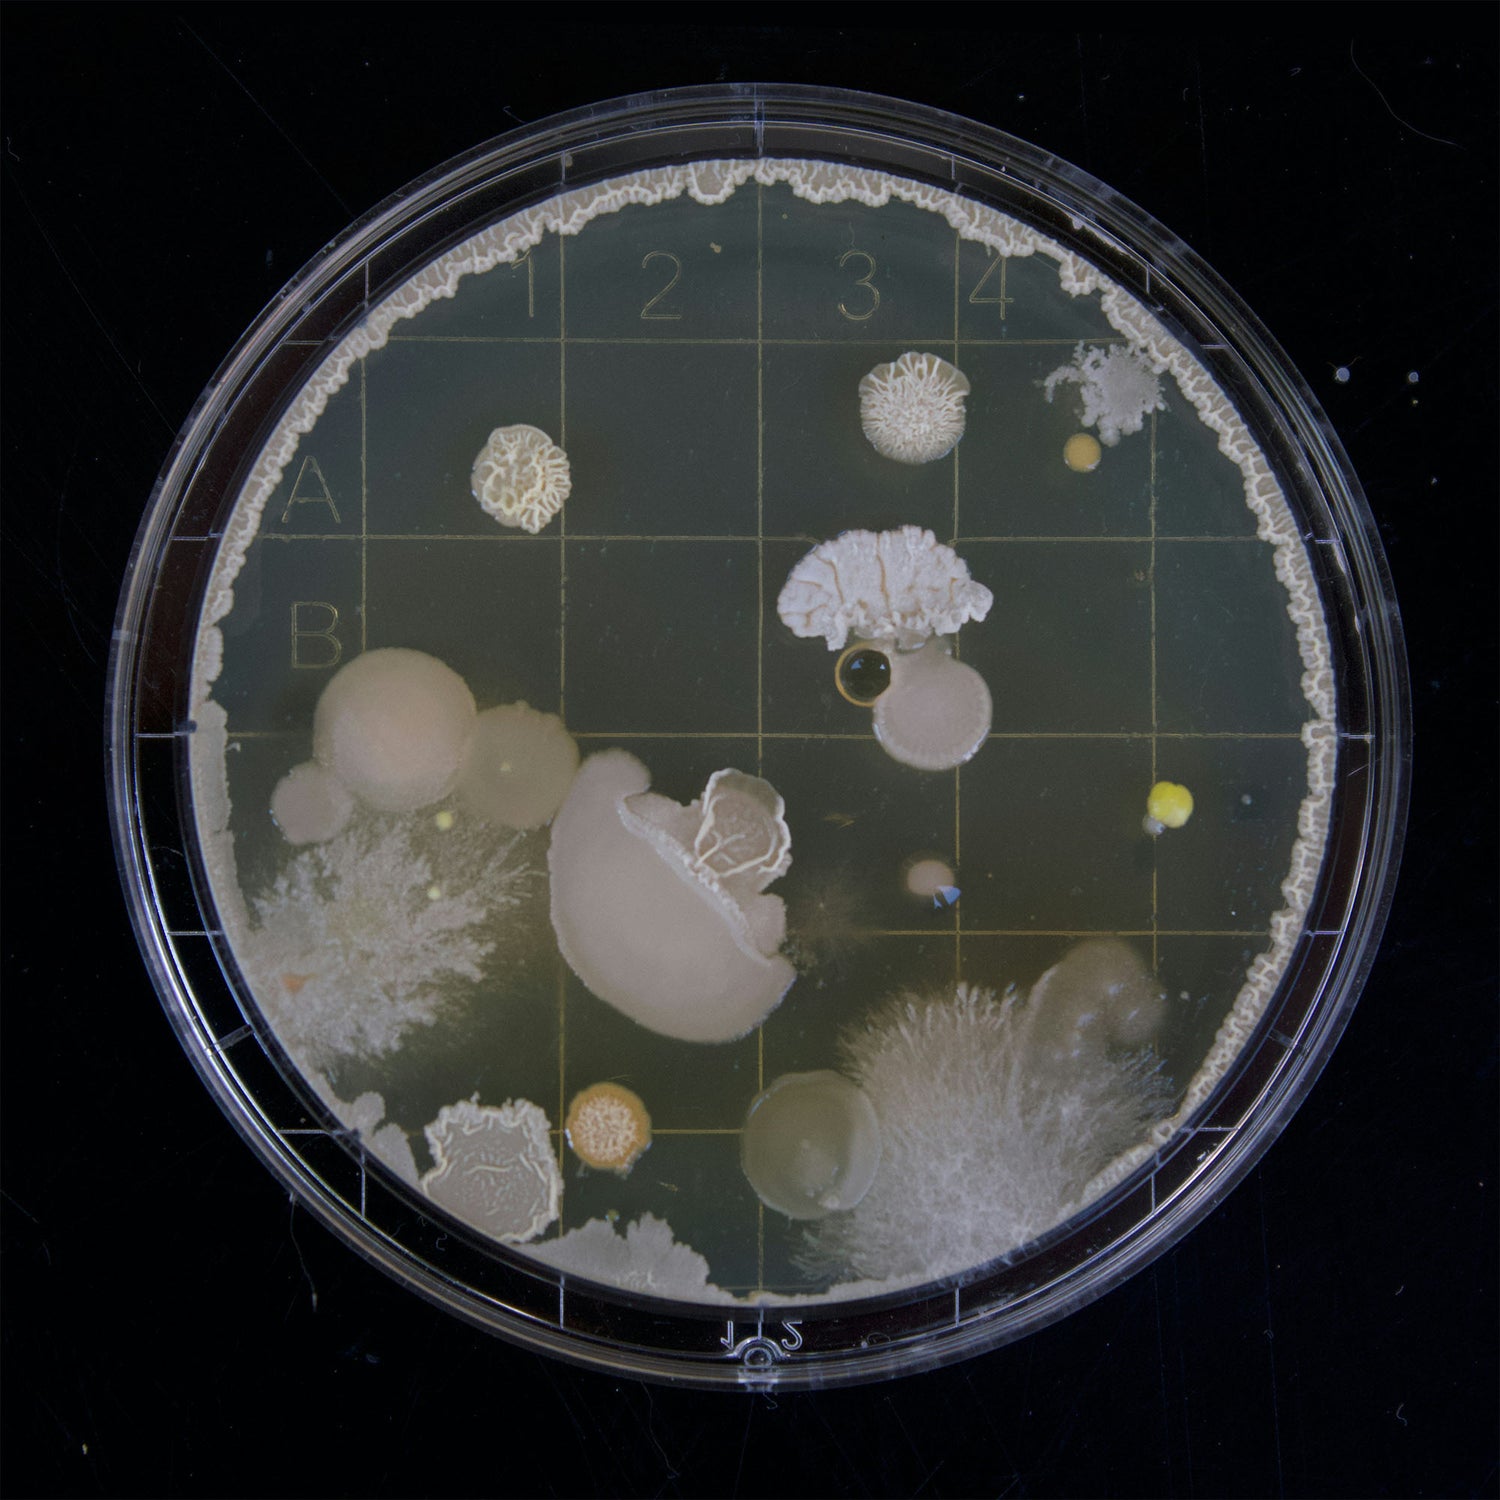

Uncovering the Truth About Human Health
Maria leads the charge in a new era of health research that aims to better understand the long-term impacts of environmental factors, pollutants, and emerging technologies on human physiology. Her findings are poised to revolutionize our understanding of human health and spark a global conversation about the future of our species.


About Maria Crisler
Maria Crisler is a pioneering expert in Clinical Microbiology and Immunology, with a deep focus on exploring how modern technology, environmental factors, and synthetic chemicals are impacting human biology. With a wealth of experience as a medical business owner, Maria bridges the gap between cutting-edge research and real-world health solutions.
Maria’s journey into holistic health began with a fascination for microbiology, leading her to uncover how pollutants—such as chemtrails, metal spraying, and industrial chemicals including silicon, strontium, tellurium and more —are entering the human body and impacting its systems on a cellular level. By using advanced technologies like electron microscopy, Maria can explore these effects in more detail than traditional studies, revealing new insights into the changes happening in the human body due to emerging technologies and pollutants.
Maria’s mission is to restore and enhance human health by offering holistic health solutions, groundbreaking research, and innovative products. Her approach combines modern science with natural healing techniques to counteract the harmful effects of technology and environmental disruption.
- Clinical Product Design & Creation
- Health Research in Microbiology and Immunology
- Environmental Toxin Research and Detox Solutions
Maria’s Research
Maria Crisler’s groundbreaking discoveries go far beyond surface-level research, providing microscopic analysis and uncovering how modern interventions are impacting human biology at its most fundamental level.
Through her research, Maria has uncovered startling evidence that contrails—often seen as harmless vapor trails from aircraft—contain chemicals such as aluminum, barium, and strontium. These metals are being released into the atmosphere and ultimately absorbed into the human body, leading to long-term health issues such as respiratory problems, neurological issues, and immune system disruptions.
Maria’s research also focuses on the rapidly expanding field of technology, examining how human biology is altered by genetic engineering, pharmaceutical interventions, and other modern technologies. Her work explores the intersection of biological evolution and technological advancements, and how these influence human health and longevity.
Using electron microscopy, Maria can analyze human blood, tissues, and other samples with incredible precision. This allows her to observe how pollutants and environmental toxins accumulate in cells, impacting their function and health.
Maria Crisler’s research goes beyond discovery—it is driven by a relentless commitment to action and real-world solutions.
As a pioneering leader in the field of health and wellness, Maria is taking bold steps to counteract the growing threats to human health with powerful, scientifically-backed solutions that directly address the root causes of today’s health crises
Her work is not just about identifying problems; it is about creating tangible, actionable solutions that restore balance to the body at the cellular level. From revolutionary supplements to cutting-edge wellness protocols, the products Maria designs are specifically crafted to detoxify the body, restore vital cellular function, and enhance overall health. These solutions are not theoretical—they are based on years of meticulous research and experimentation that offer measurable, transformative results.


Maria's Favorite Things
-
Sanki Global
Shop NowDiscover Sanki Prime your subscription hub featuring curated collections like BelAge VI, Kronuit, Inner7, Hasaki Vanilla, and Hasaki Chocolate for premium products and style insights.
-
SaunaSpace
Shop NowExperience SaunaSpace with its FireLight® technology that boosts sweat efficiency at lower temperatures while fitting any space and schedule.
-
Liver Cleanse Program
Shop NowRevitalize your liver with our 6-day, all-natural cleanse that rejuvenates both liver and gallbladder.
-
Toxin Binder
Shop NowFight daily toxins from pollutants and personal care products with our advanced detox supplement that supports organ function.
-
Ozonated Activated Charcoal
Shop NowImprove digestion with ozonated activated charcoal that absorbs toxins 10X more effectively while reducing gas and supporting cholesterol and kidney function.
-
Paratrex® II
Shop NowEnhance your cleanse with Paratrex® II, targeting harmful organisms and promoting whole-body health with immune-boosting ingredients and MicroSomal® Technology.
-
Ultimate Methylene Blue
Shop NowEnjoy our USP/Pharmaceutical Grade, formaldehyde-free methylene blue in a 59 mL glass bottle for consistent quality and potent performance.
-
MicroSomal™ Calcium Disodium EDTA
Shop NowDetoxify heavy metals with GH’s unique Microsomal Calcium Disodium EDTA, enriched with sulfur for superior mercury binding and enhanced detox support.
-
Power Plate
Shop NowHarness nano vibrations with Power Plate’s PrecisionWave frequency that challenges your body’s stability for improved fitness.
-
BluShield
Shop NowProtect your home and spaces from harmful EMF to keep your cells in coherent resonance.

Maria Crisler’s Events
Date:
March 22-23, 2025
Event:
Holistic Health & Well-Being Conference
Location:
Kensington Town Hall, London
Overview:
Maria will be presenting her revolutionary research at the Holistic Health & Well-Being Conference in London, scheduled for March 22-23, 2025 at Kensington Town Hall. This will be a pivotal moment for the health and wellness community as Maria shares detailed insights into the post-human evolution that has taken place since the release of the COVID-19 vaccine.
Watch the Event: https://www.batterseaparkevents.co/uk
- In-Depth Microscopic Analysis: Maria’s research highlights the cellular-level impacts of environmental pollutants, emerging technologies, and modern interventions on human health.
- A Bold New Perspective: Her presentation will challenge existing paradigms and offer an entirely new way of looking at human health and biology.
- Actionable Solutions: The most exciting part of Maria’s work is that she’s not just presenting the problem—she has a solution. Her research includes practical, science-backed solutions to help mitigate the effects of these disruptions on human health.
Maria’s work is set to change everything we thought we knew about human biology, offering not just answers, but real-world solutions to the growing health crises facing us today.
During this session, you’ll gain exclusive access to Maria’s cutting-edge research and have the chance to engage in meaningful discussions about the path forward for holistic health and the preservation of human well-being.

Novalytic by Abeytú Naturals
Novalytic is a "new" one and only product addressing today's toxic inorganic micro and nanotech contaminants. This Abeytu' capsule is specially formulated after two years of clinical research into what is fueling the proliferation and stabilization of synthetic pathogens.
Join Maria Crisler in Shaping the Future of Human Health
-
Volunteer Opportunities
Help advance Maria’s research and spread awareness through various volunteer roles. Whether it’s assisting with research, outreach efforts, or educational initiatives, your time and efforts will help further the mission of restoring human health.
-
Donate to the Nonprofit
Your donation supports ongoing research, holistic health solutions, and efforts to mitigate the long-term effects of environmental pollutants, emerging technologies, and other modern health threats. Your generosity helps fuel critical research and health interventions for the future of human well-being.
-
Become a Partner
Collaborate with Maria’s team to help expand the mission and drive change. As a partner, you will work directly with Maria and her team to amplify efforts, develop new initiatives, and support the mission to improve global health.
-
Become a Vendor
Join the movement as a vendor partner. By collaborating with Maria’s team, you can provide essential products or services that align with the mission to enhance human health and wellness.
Contact